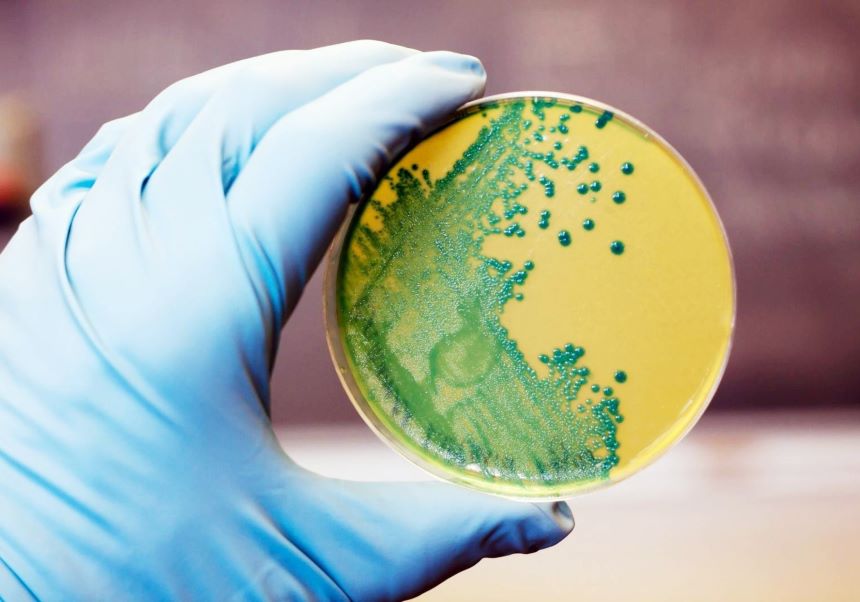

Un equipo de investigación, liderado por la profesora Julia Marín, del departamento de Bioquímica y Biología Molecular de Facultat de Cièncias Biològiques de la Universitat de València (UV) ha descubierto el potencial de una combinación de enzimas para hacer frente a la listeria, una bacteria de notable riesgo para la salud alimentaria. El trabajo, liderado por el Instituto de Agroquímica y Tecnología de Alimentos (IATA, CSIC), ha dado lugar a una patente de aplicación a la lucha contra este patógeno. El nuevo sistema elimina hasta el 99,99% de sus células en ensayos.
Entre los enemigos que ponen en riesgo los alimentos de consumo, Listeria monocytogenes destaca como uno de los patógenos más peligrosos, causando decenas de muertes cada año. Puede contaminar desde carnes procesadas hasta productos lácteos no pasteurizados y alimentos listos para consumir; tiene capacidad para sobrevivir en condiciones extremas, con bajas temperaturas y altos niveles de salinidad, y es responsable de enfermedades graves, especialmente en personas inmunodeprimidas, mujeres embarazadas, adultos mayores y niños. Además de generar residuos, los métodos tradicionales para combatirla pueden resultar nocivos para la salud, y su control representa un desafío para la industria alimentaria
Ahora, un equipo de investigación del Instituto de Agroquímica y Tecnología de Alimentos (IATA, CSIC), en el Parc Científic de la UV, en colaboración con el Instituto de Biología Molecular y Celular de Plantas (IBMCP, CSIC-UPV), ha encontrado una fórmula para luchar contra esta bacteria mediante la combinación de dos enzimas. “Se trata de un sistema inocuo y libre de residuos nocivos, que elimina eficazmente hasta el 99,99% de las células de listeria en ensayos y que posee un gran potencial para su aplicación directa en alimentos”, comenta Julia Marín, bioquímica, investigadora de la Universitat de València en el IATA y líder del estudio que aparece publicado en la revista Biomolecules. “Separadas, estas enzimas tienen una eficacia limitada, pero juntas logran un efecto sinérgico excelente contra Listeria monocytogenes, debido a que presentan distintos modos de acción”, añade la científica.
Esta combinación ha permitido además reducir las concentraciones de glucosa oxidasa y endolisina para lograr un efecto antimicrobiano, minimizando posibles efectos adversos sobre las características y propiedades organolépticas de los alimentos. “La estrategia empleada es muy efectiva para la limpieza de superficies en entornos alimentarios, y presenta un gran potencial para su aplicación directa en alimentos en el futuro”, añade Julio Polaina, integrante del equipo de investigación del IATA-CSIC.
Además, “la probabilidad de que las bacterias desarrollen resistencia a ambas enzimas de forma simultánea es baja, dada la naturaleza combinada y específica del tratamiento”, concluye Polaina. “Este enfoque no sólo es eficaz, sino también respetuoso con el medio ambiente. A diferencia de los desinfectantes químicos tradicionales, estas enzimas no son tóxicas, ni tampoco generan residuos peligrosos”, amplía José Antonio Darós, investigador del CSIC en el IBMCP que participa en la investigación.
“El ‘cóctel enzimático’ empleado en esta investigación representa un método novedoso, con mucho potencial como agente desinfectante y como conservante en alimentos para las empresas del sector”, resume David Talens, investigador del IATA-CSIC participante en el trabajo.
Los resultados obtenidos han dado lugar a una patente titularidad del Consejo Superior de Investigaciones Científicas (62,5%), la Universitat de València (25%) y la Universitat Politècnica de València (12%). “El tratamiento desarrollado supone una revolución potencial en la lucha contra los patógenos alimentarios. Aunque es necesario seguir investigando para escalar estos resultados a nivel industrial, las perspectivas son alentadoras.”, coinciden los miembros del equipo científico.
Referencia:
Talens-Perales, D.; Daròs, J.-A.; Polaina, J.; Marín-Navarro, J. Synergistic Enzybiotic Effect of a Bacteriophage Endolysin and an Engineered Glucose Oxidase Against Listeria. Biomolecules 2025, 15, 24. DOI: https://doi.org/10.3390/biom15010024












